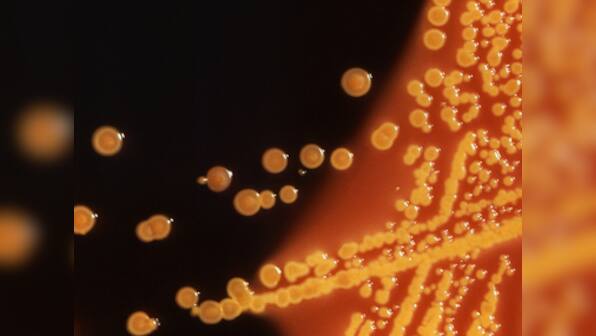

Washington: Five people have died in a major E coli outbreak in the US involving romaine lettuce, with 197 cases reported across 35 states, according to the Centres for Disease Control and Prevention (CDC). [caption id=“attachment_4492669” align=“alignleft” width=“380”] Colonies of E. coli bacteria[/caption] The outbreak was first reported on 13 March, reported CNN. The US Food and Drug Administration (FDA), which is investigating the outbreak alongside the CDC, believes that the probable link to all these illnesses is romaine lettuce sourced from the winter growing areas in and around the Yuma region in Arizona. Romaine lettuce from this area is no longer available in stores or restaurants, according to the FDA. Symptoms, which begin about three to four days after consuming the bacteria, can include watery or bloody diarrhea, fever, abdominal cramps, nausea and vomiting, according to the CDC. Most people infected by the bacteria get better within five to seven days. Of the total 187 patients for whom information was available, 89 or 48 percent were hospitalised, including 26 who developed a type of kidney failure called hemolytic uremic syndrome. This is the largest outbreak of its kind since a deadly E.coli outbreak in 2006 that was linked to spinach, CNN reported. Unlike spinach, which is often cooked, romaine and lettuce in general, is more common as a culprit in E.coli outbreaks because it’s eaten raw.
Five people have died in a major E coli outbreak in the US involving romaine lettuce, with 197 cases reported across 35 states, according to the Centres for Disease Control and Prevention (CDC).
Advertisement
End of Article

)

)
)
)
)
)
)
)
)



